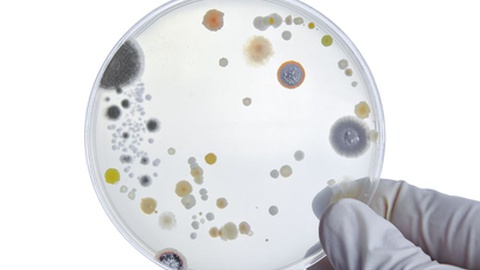
None

Sismo de magnitude 4.1 registado a norte da Madeira

Foto IGN
O Instituto Nacional de Geografia de Espanha registou um sismo de magnitude 4.1 a norte da ilha da Madeira pelas 19h24 (UTC) desta sexta-feira, 12 de Dezembro.
De acordo com os dados disponibilizados, a actividade sísmica ocorreu a uma profundidade de 30 km, com epicentro nas coordenadas 34,7885°N, 16,5968°W, no oceano Atlântico, a norte da Madeira.
Mais Casos
A carregar...
Não existe mais conteúdo
Carregar mais notícias
Erro ao carregar mais conteúdo